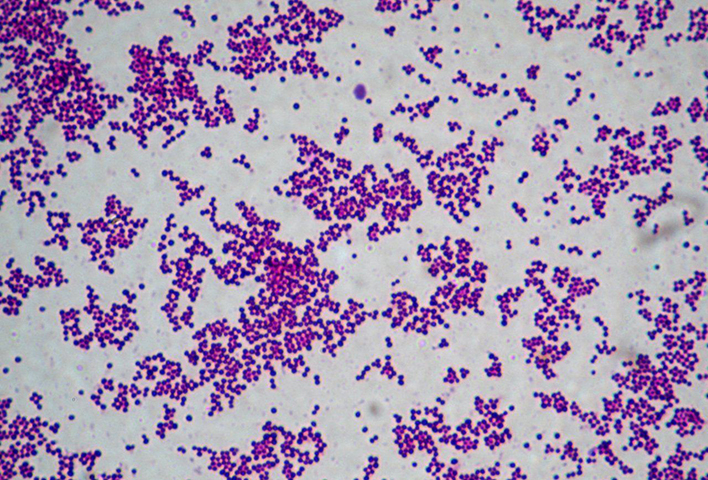

Что такое золотистый стафилококк?
Микроорганизмы, известные как золотистый стафилококк, представляют собой круглые грамположительные бактерии, которые могут существовать как в присутствии кислорода, так и без него. Они обычно формируются в виде колоний, напоминающих пояса, и являются основным патогеном в семействе стафилококков, вызывая разнообразные заболевания у людей и животных. Золотистый стафилококк может быть обнаружен в различных продуктах.
Отравление (стафилококковый энтеротоксикоз) происходит после употребления сильно загрязненной пищи, где бактерии размножаются и вырабатывают большое количество токсинов. Стафилококковые микроорганизмы, находящиеся в пище, вызывают это заболевание.
Семейство стафилококков включает в себя 19 различных видов и подвидов. Несмотря на то, что стафилококки обычно обитают на коже многих различных видов млекопитающих и птиц, а также на различных поверхностях окружающей среды, основным источником стафилококков, вызывающим отравление через пищу, считается человек. Эти микроорганизмы могут находиться в носу, пищеводе, волосах и на коже здоровых людей, а также в большом количестве в порезах, волдырях и абсцессах.
Продукты питания, которые могут быть опасны из-за возможного содержания золотистого стафилококка:
- Пищевые продукты, такие как мясо, рыба и изделия из них (фарш, колбасы, ветчина)
- Продукты из молока, включая сыр и другие молочные продукты (сливочные соусы, взбитые сливки, мороженое, концентрированное и сухое молоко, пудинги)
- Соусы на основе майонеза и блюда, приготовленные с его использованием (оливье, яичный салат и т. д.);
- Десерты, наполненные взбитыми сливками.
- Блюда, которые были хранены вместе с зараженными продуктами.
Как происходит заражение продуктов питания стафилококками?
У людей заболевание возникает после употребления пищи, в которой присутствовали живые бактерии стафилококков или оставленные ими энтеротоксины.
Наиболее частой причиной заражения пищи являются люди, которые являются носителями разнообразных заболеваний, вызванных стафилококками. Кроме того, бактерии могут быть переданы здоровыми людьми, у которых стафилококковые бактерии обитают на слизистых оболочках и в кишечнике.
В настоящее время стафилококки все чаще обнаруживаются на кухонном оборудовании и инвентаре заведений общественного питания. Ситуация образует некий замкнутый круг: зараженные люди передают инфекцию приборам и оборудованию, которые в свою очередь могут заразить пищевые продукты и других людей.
При обилии стафилококков в окружающей среде они часто попадают в различные продукты питания. Пища может стать источником передачи стафилококка при наличии большого количества бактерий и образовании энтеротоксина. Токсин появляется, когда на каждый грамм пищи приходится приблизительно 200 000 стафилококков. Размножение стафилококков (и образование энтеротоксина) происходит быстрее при оптимальной температуре (34-8 °C), но этот процесс также не прекращается при комнатной температуре.
Как предотвратить пищевое отравление, вызванное золотистым стафилококком?
Превентивные меры должны способствовать предотвращению роста и размножения бактерий. Строгое соблюдение правил гигиены является основным предпосылкой для пищевой промышленности. Поскольку человек является основным переносчиком стафилококков, он может способствовать вторичному загрязнению при контакте с пищевыми продуктами. Люди с травмами, ожогами, рубцами, вероятнее всего, будут участвовать в передаче бактерий.
Инфицирование может происходить через контакт с руками, через капельки воздуха или через загрязненные инструменты. Также не редки случаи прямой передачи бактерий от человека к человеку. Также рекомендуется избегать длительного хранения еды и лучше готовить ее непосредственно перед употреблением.
Еще одним важным способом предотвращения является продуманная термическая обработка продуктов.
Важно учитывать, что с точки зрения технологии, содержание соли выше 12%, содержание сахара выше 60%, рН ниже 5, и температура ниже 7° С помогают предотвратить развитие стафилококка.
В настоящее время нет возможности пройти вакцинацию от этого заболевания.
Насколько опасно заражение стафилококками из пищевых продуктов?
Золотистый стафилококк — один из ключевых патогенов, обнаруживаемых в готовых к употреблению продуктах. Отравление, вызванное этим микроорганизмом, может привести к ослаблению организма. Обычно это заболевание считается легким и проходит само по себе. Смертность от золотистого стафилококка невелика, но 14% пострадавших требуют госпитализации согласно статистике.
Стафилококковая инфекция развивается при температуре от 7 до 48 градусов по Цельсию. Поскольку рост этой бактерии обычно затрудняется конкуренцией со стороны других организмов, стафилококки успешно размножаются в среде, где относительно мало других бактерий, например, в продуктах с высоким содержанием соли и сахара, что препятствует размножению других микроорганизмов.
Энтеротоксины, продуцируемые стафилококками, обладают высокой устойчивостью к нагреву. Поскольку нормальная температура приготовления не разрушает эти токсины, а продукты, содержащие стафилококковый энтеротоксин, обычно имеют тенденцию выглядеть и смаковать нормально, то профилактические меры для предотвращения роста золотистого стафилококка имеют решающее значение для обеспечения безопасности продукта.
Методы определения стафилококков в пищевых продуктах
Для обнаружения золотистого стафилококка в продуктах питания используют специальные питательные среды, которые содержат отборные ингредиенты, задерживающие рост этих микроорганизмов. Например, азид натрия, теллурит калия, хлорид лития или определенные антибиотики, такие как полимиксин и неомицин. Они могут быть обнаружены с использованием микроскопических методов исследования.
Частые вопросы
Какие продукты питания чаще всего заражаются стафилококками?
Чаще всего продукты, такие как молоко и молочные продукты, мясо, яйца, майонез, салаты и другие продукты, требующие хранения в холодильнике, могут быть заражены стафилококками.
Какие условия способствуют размножению стафилококков в пище?
Стафилококки могут размножаться в продуктах при комнатной температуре, особенно если продукты хранятся длительное время без холодильника. Также недостаточная термическая обработка пищи может способствовать размножению стафилококков.
Как можно предотвратить заражение пищи стафилококками?
Для предотвращения заражения пищи стафилококками необходимо соблюдать правила гигиены при приготовлении пищи, хранить продукты при низкой температуре, тщательно готовить и обрабатывать продукты перед употреблением.
Полезные советы
СОВЕТ №1
Тщательно мойте руки перед приготовлением пищи и после контакта с сырыми продуктами, чтобы предотвратить передачу стафилококков на продукты.
СОВЕТ №2
Храните пищу при правильной температуре, чтобы замедлить рост бактерий, включая стафилококки. Перед употреблением нагревайте пищу до достаточно высокой температуры, чтобы уничтожить возможные бактерии.